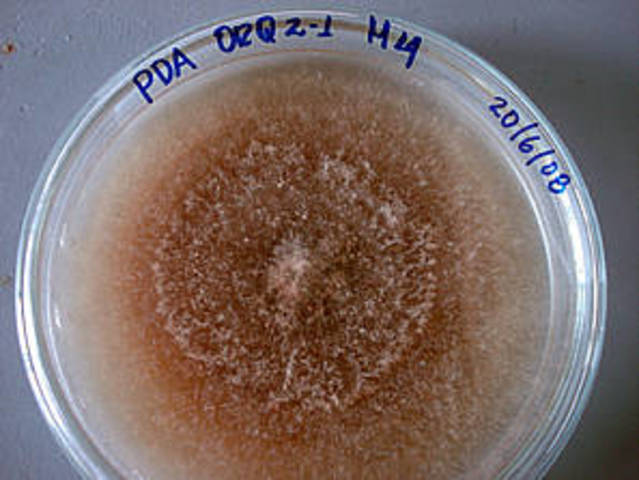
Hongos
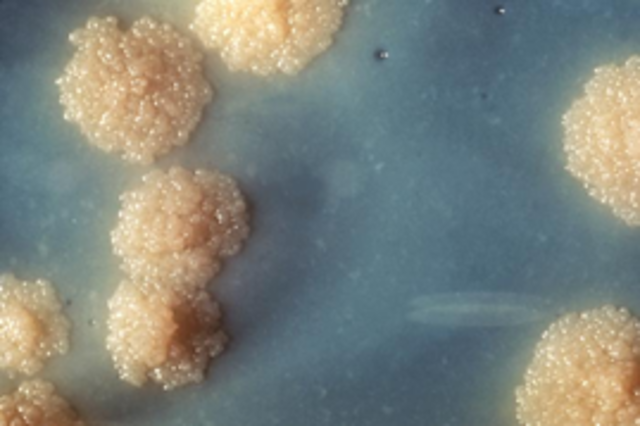
Mycobacterias

-
Los chinos inmunizar a las personas contra la viruela utilizando costras secas soplado en las fosas nasales. Este procedimiento evoluciona a lo largo de los siglos para convertirse en la introducción de material en el brazo.
-
En un intento de proteger a sus ciudadanos de la ciudad establece una política que nadie puede entrar en la ciudad de Venecia hasta que haya transcurrido un período de espera determinado. Aunque la razón para elegir el período de 40 días no se conoce
-
Francisco López de Villalobos, escribe un poema en latín sobre la sífilis, convirtiéndose en el primer médico en describir la enfermedad, que él se refiere como las buvas
-
Girolamo Fracastoro publica “De contagione”, en el que propone que las infecciones y las epidemias son causados por "seminaria", o semillas de la enfermedad.
-
Andrea Cesalpino da primera clasificación científica de las plantas, sobre la base de los frutos y raíces. También descubre vetas de plantas y describe la estructura de las semillas y la germinación.
-
Crédito por lo general se da a Hans Jansen y su hijo Zacarías Jansen.
-
Gaspard Bauhin utiliza nombres binomiales en la clasificación de las plantas.
-
Jean Beguin publica un tratado sobre la química que utiliza la palabra fermentum para referirse al agente necesario para iniciar la fermentación, tales como la conversión de pasta de cereales para pan.
-
Robert Hooke publica Micrographia con dibujos de los organismos. Se introduce el término "célula" para describir la apariencia microscópica del corcho.
-
Cherubin d'Orleans diseña el primer microscopio binocular.
-
Francesco Redi realiza uno de los experimentos más tempranos controlados para investigar si es o no la vida surge espontáneamente de sustancias inanimadas.
-
Antony van Leeuwenhoek, es el primero en ver y describir protozoos, de los cuales dijo: "animaitos muy pequeños". También ve un alga verde, posiblemente Spirogyra y glóbulos rojos en la sangre humana, y señaló que causan el enrojecimiento de
sangre. -
En la provincia de Champagne, Francia, añade azúcar para un barril de vino para comenzar una segunda fermentación. El vino resultante, espumoso o efervescente, se le da el nombre de champagnen
-
Johann Becher descubre que el azúcar es necesaria para le fermentación.
-
Denys Papin describe un precursor de la autoclave cuando detalla de un "motor para huesos suaves " que utiliza para obtener la gelatina de huesos de animales.
-
John Ray publica Methodus plantarum nova, en el que se ofrece la primera definición de "especie" como un conjunto de individuos cuya reproducción produce nuevos individuos similares a ellos mismos
-
Carlos Linneo (Carl von Linne) presenta Systema naturae, su primera clasificación de las plantas. Sus descripciones de clases de plantas con flores se basa en sus órganos "masculinas"
-
Carolus Linnaeus escribe Genera plantarurn, describiendo 18.000 especies de plantas y nombrándolos sobre la base de una nomenclatura binomial.
-
John Needham Turberville informa experimentos llevados a cabo en la generación animaculada de "microscópicas" en infusiones de tejido vegetal o animal.
-
Carolus Linnaeus amplía su sistema de nomenclatura binomial y clasificación de las plantas mediante el establecimiento no sólo las especies y géneros, sino también clases y órdenes.
-
Carolus Linnaeus publica plantarum Especies, en el que da un género y nombre de la especie a las 5.900 plantas se ha clasificado, así firmemente el establecimiento de un sistema binomial de nomenclatura.
-
Otto Frederik Muller publicó como podría ser la primera descripción de un microorganismo ahora nombrado bacteria.
-
Benjamin Jesty realizo las primeras prácticas de vacuna de viruela, experimentando en su esposa e hijos al ponerles material de ubre de vaca y sobreviviendo así a una epidemia de viruela.
-
Jan Ingenhousz demuestra que las plantas producen "aire vital" (oxígeno) en la luz del sol pero que sin luz que producen "aire fijo." También muestra que las plantas obtienen carbono de la atmósfera y no desde el suelo.
-
Carl Wilhelm Scheele aísla ácido láctico a partir de leche agria. También descubre varios otros compuestos de importancia biológica.
-
Jean Senebier informa que se necesita luz para la restauración de aire por la planta crecimiento.
-
Otto Frederik Müller hace el primer avance significativo en el estudio de bacterias desde las observaciones de Antonie van Leeuwenhoek de 1683, cuando él describe con precisión de 150 especies de bacterias de acuerdo con la morfología.
-
Antoine Lavoisier intenta el equilibrio químico de todas las sustancias que intervienen en la fermentación, que él cree que es una reacción puramente química.
-
Erasmus Darwin, abuelo de Charles Darwin y tanto Francis Galton, publica Zoonomía, en el que propone una "transmutación" de las formas de vida.
-
Guyton de Morveau y William Cruikshank utilizan "ácido oxymuriatic" (cloro rebautizada en 1811 por Humphry Davy) para el saneamiento del agua potable.
-
Karl Burdach primero en utilizar el término "biología" para explicar los atributos morfológicos, fisiológicos y psicológicos de los seres humanos.
-
Louis-Nicolas Vauquelin le da el nombre de "asparagina" a una sustancia que aislados de espárragos. Aunque no se dio cuenta en este momento, desconocen que son los primeros aminoácidos que se encuentran.
-
Jons Berzelius caracteriza como orgánicos los compuestos derivados de cualquiera de los organismos vivos o muertos o aquellos químicamente relacionados con tales compuestos, todas las demás sustancias son compuestos inorgánicos.
-
Nicolas Appert comienza el embotellado (enlatado) de alimentos, para encontrar una manera de conservar los alimentos que se pueden usar el ejército, Se informa de experimentos llevados a cabo más de dos décadas que muestran los alimentos se puede conservar con éxito a través de un proceso de calentamiento, lo que conduce a las técnicas modernas de enlatado
-
William Wollaston aísla el aminoácido cistina de una piedra en la vejiga
-
almidón Gottlieb Konstantin Kirchhoff produce glucosa por ebullición de almidón en presencia de ácido sulfúrico.
-
Augustin-Pyrame de Candolle usa la palabra "taxonomía" para la clasificación de las especies en su enciclopedia de las plantas
-
Fermentación Joseph Gay-Lussac comprueba y corrige los datos de Antoine Lavoisier sobre la fermentación y escribe la primera versión de lo que viene a ser conocido como la Ecuación de Gay-Lussac para la fermentación alcohólica.
-
Louis Jacques Thénard descubrió el peróxido de hidrógeno y demostró que los tejidos de las plantas y animales lo descomponen
-
Henri Braconnot hierve aserrín y corteza con ácido y obtiene la glucosa.
-
Bory de San Vicente incluye una tabla titulada “Tableau des Ordes, des Familias et des Géneros de Microscopiques” en su libro Myclogia Europia. En donde enumera varios organismos, de los cuales ahora se sabe que son bacterias. Estos incluyen Espirilla y Vibrio.
-
Augustin Pierre Dubrunfaut hace un extracto acuoso de malta que convierte el almidón en azúcar.
-
Robert Brown descubre el núcleo de una célula de planta.
-
Anselme Payen y Jean Francois Persoz trataron extracto de malta con alcohol y obtuvieron un polvo blanco, el cual convertía el almidón en azúcar, lo llamaron diastasa, la diastasa es la primera sustancia en ser aislada, la cual después es referida como una enzima.
-
Anselme Payen aísla una sustancia de la madera la cual nombra “celulosa”, demuestra que se puede descomponer para formar glucosa.
-
Theodor Schwann obtiene pepsina del estómago de los cerdos. Esta es la primera sustancia en ser aislada de animales para después ser llamada una enzima.
-
Theodor Schwann observa la multiplicación de levadura y la nombra Saccharomyces.
-
Christian Gottfried Ehrenberg publicó un reporte sobre infusión animal en donde establece diferentes grupos sobre los tamaños y formas de las bacterias.
-
Gerardus Johannes Mulder asigna el nombre “proteína” a las sustancias que él cree forman la unidad básica de los materiales albúminos.
-
Robert Chambers publico el libro de Vestigion de historia natural de la evolución donde habla que se ha efectuado a partir de un reducido número de estirpes originales que han seguido líneas filogenéticas paralelas.
-
Karl Theodor Ernst von Siebold les da el nombre de Protozoos a animales cuya organización es reducida a una célula.
-
La fructosa fue descubierta por el químico francés Augustin-Pierre Dubrunfaut, cuando se dio cuenta de que la rotación específica de la solución acuosa de azúcar cambia con el tiempo que se encuentra en muchas plantas.
-
Hugo von Mohl demostró que el protoplasma es la fuente de los movimientos, llamándolo 'utrículo vital' y es el primero en describir el comportamiento del protoplasma en la división celular.
-
Aloys Pollender fue un médico alemán que se le atribuye el descubrimiento de la etiología de ántrax.
-
Ferdinand Cohn utiliza colorantes como el carmín y hematoxilina para marcar secciones histológicas.
-
Maximilian Perty crea un género llamado Sporonema y formula una clasificación de bacterias ya sea como espiral o rectos y flexuosa o no.
-
Heinrich Georg Friedrich Schroder and Theodor von Dusch desarrollaron un método de esterilización de aire por filtración a través de algodón esto para la microbiología fue un importante descubrimiento fue la base de los estudios posteriores de Louis Pasteur.
-
William Henry Perkin sintetiza el colorante malva, dando lugar a diversos colorantes sintéticos, que se utilizaran posteriormente en la marca de materiales biológicos.
-
Carl Wilhelm von Nágeli coloca las bacterias en el grupo Schizomycetes.
-
Louis Pasteur a través de un experimento, demostró de manera concluyente la imposibilidad de la generación espontánea de la vida como defienden los abiogenistas, es decir; describe la fermentación del ácido butírico y señala que las bacterias fermentan viven sin oxígeno libre. Posteriormente se aplica el término anaerobias a tales bacterias.
John Hogg postula el tercer reino primigenium o Protoctista para los protozoos, protófitos y formas simples.
Max Johann Sigismund Schultze señaló su identid -
Casimir Joseph Davaine realiza experimentos sobre la causa del ántrax se refiere a las bacterias como Bacteridi.
-
Gregor Mendel's propone que cada característica existe como un factor de unidad de partículas.
-
Ernst Haeckel clasifica a los organismos en : plantae, animalia y protista.
-
Joseph Lister publica el uso de acido carbonilico como antiséptico.
-
Louis Pasteur confirma que las bacterias convierten el alcohol etilico en vinagre.
-
Joseph Davaine clasifica las bacterias en; vidrio, bacteridium y spirillum.
-
Herman Hoffman utiliza un tinte vegetal para observar las bacterias al microscopio
-
Louis Pasteur identifica las bacterias que tienen etapas latentes, cuerpos retractiles y que son mas resistentes al calor.
-
Adolf Baeyer sugiere que en la fermentacion láctica en el tejido muscular ocurre la glucolisis.
-
Ferdinand Cohn clasifica las bacterias en el reino animal y denomina a la bacteriologia como ciencia independiente.
-
Ernest Abbe diseña un condensador para el microscopio. Se propone que los 4 enlaces del carbono es debido a su forma tetraedrica.
-
Armauer Hanse atribuye la enfermedad de la lepra a un microorganismo.
-
Oscar Brefeld, instituye las reglas para obtener un cultivo puro de hongos con una sola espora.
-
Eduar Ffliigr concluye que las proteinas de las celulas cambian por lo que estan vivas.
-
Los experimentos combinados de Louis Pasteur, John Tydall y Ferdinand Cohn promueven la refutacion de la teoria de la generacion espontanea.
-
Joseph Lister obtiene el primer cultivo puro de una bacteria Sterptococcus lactis.
-
P.Miquel encontro un bacilo termofilo que puede soportar temperaturas mayores a 70°C.
-
Luis Pasreur emplea microorganismos para vacunar a gallinas con colera
-
Luis Pasteur y asosiados descubren vacuna contra antrax.
-
August Weismann, descubre una complja teoria de la herencia.
-
Elie Mmetchnikoff, descubre a los fagosomas asi como llamo macrofagos a los leucocitos.
-
Alfred Fisher de muestra la existencia de pared celular bacteriana.
-
Camillo Golgi descubre el aparato de Golgi.
Albrecht Kossel purifica acidos nucleicos. -
Joseph Schroeter clasifica las bacterias en 3 ordenes y 26 generos.
-
Eduard Joseph y Louis Beneden, descubren un numero constante de cromosoas entre la misma especie.
-
George Henry desarrolla la teoria de la inmunidad humoral.
-
Richard Alfmann encuentra en el nucleó ácidos nucleicos.
-
S. Winogradski, descubre que apartir de CO2 las celulas producen energia y carbono.
-
Las bacterias presentan Quimiotaxis.-Martinus Beijerinck.
-
Emil Fisger encuentra la relacion enzima sustrato.
-
Max Griiber descubre anticuerpos en la sangre que aglutina las bacterias.
-
A. Meyer introduce metodos microquimicos para el estudio de bacterias.
-
Edwin Frink demuestra que las bacterias causan varias enfermedades de plantas. Walter Stanborough y Theodor Boveri proponen que la division celular podria exlicar los principios mendelianos.
-
Se comienza a diferenciar los neumococos de los estreptococos. Martin Beijerink, utiliza las bacterias como herramienta de investigacion genetica.
-
Se comienza a diferenciar los neumococos de los esterptococos. Martin Beijerink utiliza las bacterias como herramienta de investigacion genetica.
-
Grimme y Fischer, descubren que las bacterias tienen una membrana citoplasmica.
-
L.Loeb informa que algunas bacterias provocan la cuagulacion de la sangre. William Baterson sugiere que un solo cromosoma contiene mas de una unidad genica.
-
Cjaim Azriel aisla una bacteria que produce una mayor cantidad de acetona por fermentacion. Frederick Donnan descubre un equilibrio membranal que permite el paso de iones atraves de la membrana.
-
-
Tomas Hunt et al. Presentan si interpretacion de la teoria cromosomica o de la herencia.
-
D'Arcy Wentwoeth publica una discusion acerca del crecimiento y estructura de los organismos.
W.A Jacons y sus colegas estudian las propiedades bacterianas, esto causa la creacion de los antibacteriales. -
Felix Herelle descubre los bacteriofagos.
-
Se oublica el primer anaisis del crecimiento bacteriano por Robert Earle Buchanan
-
SAB crea na nueva clasificacion para las bacterias. Descubrimiento de la prueba de la catalasa para la identificacion de las bacterias anaerobias y aerobicas
-
Evert Gorter y F. Grendel
Concluyen que la membrana de células de sangre están formadas en bicapa lípídica. -
Frederic Parker, J., y Robert N. Nye
Crecen vacuna para viruela (vaccinia virus). Llevándola al éxito a través de 11 culturas. -
Andre Gratia
Descubre Bacteriocinas (Proteínas que se especifican por plásmidos). -
Everitt George Dunne Murray R. A. Webb, y M. B. R.
Aíslan Bacterium monocytogenes, causante de la enfermedad de Listeriosis en animales y humanos. -
Karl Landsteiner y Philip Levine identificaron los grupos de sangre MNP.
-
James Batcheller Sumner
Cristaliza la enzima ureasa. -
Alexis Carrel
Encuentra que el oncovirus Rous sarcoma crece en fragmentos de tejidos. -
Gaston Leon Ramón y Christian Zoeller
utilizan toxoide tetánico para lograr la inmunización activa en los seres humanos contra el tétanos. -
Herman Meyerhof
Descubre que los rayos X causan mutaciones genéticas en mosca de fruta. -
Otto Meyerhof
Descubre la enzima Hexoquinasa, encontrada en extracto de levadura. -
K. Dewes
Primera demostración de fijación de nitrógeno por las algas verde-azules. -
Albert Szent - Györgyi
Aísla un "factor de reducción " de la corteza suprarrenal que él llama "ácido hexurónic -
Juda Quastel y W.R. Wooldrige
Descubrieron los inhibidores de las enzimas cuando encontraron que el malonato inhibía la acción de la deshidrogenasa succínico. -
V. Burke y Barnes MW
Concluyen que las diferencias de la permeabilidad de la pared celular son responsables de la decoloración más rápida de bacteria Gram-negativas que de Gram-positivas. -
Alexander Fleming
Descubre una sustancia antibacteriana, penicilina. -
Max Theiler
Muestra el suero inmune para la fiebre Amarilla -
Phoebus Levene determina que desoxirribosa es un componente de un tipo de ácido nucleico. Los nombres de ácido ribonucleico (ARN ) y ácido desoxirribonucleico ( ADN) de este modo se establecen.
-
Samuel P. Bedson y GT Western aíslan Chlamydia psittaci , el agente causante de la psitacosis , mediante la inoculación de muestras infecciosas de los seres humanos y aves en periquitos.
-
Denisovich Lysenko
Afirma que la vernalización sostiene que una solo exposición al frío confiere un cambio permanente. -
William J. Elford
Desarrolla una membrana de colodión, compuesto de nitrato de celulosa con diferentes tamaños de poro. -
Ernest William Goodpasture y Alice Miles Woodruff
Introducen el uso de huevo de gallina fertilizados para el cultivo de virus animales. -
HLA Tarr y Harold Hibbert
Encuentran que un cultivo puro de Bacteria xylinum ( xylinus Acetobacter ) produce un compuesto idéntica a la celulosa. -
Richard Shope
Este es el primer descubrimiento de un tumor sólido en animales causada por un virus. -
RA Stewart y KF Meyer
Desarrollaron un medio sintético que retarda el crecimiento de la mayoría de las bacterias y los hongos para facilitar los esfuerzos para aislar coccidioides del suelo. -
Max Knoll y Ernst Ruska
construyen el primer microscopio electrónico, mientras que E. Briiche y H. Johannson obtener las primeras imágenes con el microscopio electrónico electrostática. -
Karl Lohmann
Determina la estructura química de ADP ( adenosina 5'diphosphate). -
Walter Norman Haworth
Sintetiza y determina la estructura de la vitamina C. -
Martin Schlesinger
-
Gustav Embden
-
Wilson Smith, Christopher Andrews, y Patrick Laidlaw
El virus se conoce como la gripe A -
Samuel P. Bedson y OW Bland
-
M. Lewis
-
Ladislao Laszlo Marton
Se reporta el primero en utilizar el microscopio electrónico. -
Edgar Altenburg
-
C.Lindegren
-
Edward Holbrook Derrick
-
Wilson Smith
-
Wendell Meredith Stanley
-
Paul Karrer
-
HA Barker
-
Informan el aislamiento de mutantes de bacteriófagos de Salmonella enteritidis.
-
Albert Bruce Sabin y PK Olitsky
-
E. Chatton
-
James Hillier
-
Ladislao Marton
Se publican las primeras fotografías del microscopio electrónico. -
Arne Wilhelm Tiselius
Desarrolla la técnica de electroforesis -
Manfred von Ardenne
-
William Thomas Astbury y Florencia Ogilvy
Obtienen la primera difracción de rayos X con fotografías de ADN -
H. Jost y H. Emde
-
Daniel Bovet
Primeros fármacos antihistamínicos. -
Grupos de investigadores demuestran que el ácido nucleico está presente en virus animales.
-
-
HA Barker, Samuel Ruben y Martin David Kamen
-
Howard Florey
-
Descubren que la presencia de glucosa en el crecimiento medio inhibe la producción de deaminases de aminoácidos.
-
Carl Robinow
Utiliza una modificación de la coloración de Giemsa en núcleo bacteriano. -
Claude E. Zobell
Concluye que la unión de las bacterias a las superficies sólidas influye en su crecimiento. -
Salvador Luria y Max Delbrück
Publican prueba estadística que la mutación bacteriana es un evento espontáneo. -
Monroe D. Eaton, Gordon Meiklejohn y William Van Herick
-
-
Joshua Lederberg y Edward L.
Nace el término conjugación: la transferencia de información genética de una bacteria -
Woutera van Iterson
-
Joshua Lederberg
Primer mapa genético de Escherichia coli. -
Descubrimiento de CoA.
-
Alexander Todd
Bioquímica: se confirman las estructuras del ATP y ADP, y su síntesis. -
Giuseppe Brotzu
-
Thomas F. Anderson e, A. L. Houwink
-
William G. Cochran
-
Luca L. Cavalli-Sforza
Se descubre la primera cepa de Escherichia coli que transfiere los marcadores cromosómicos. -
Luca L. Cavalli-Sforza
-
Retkulum Albert Claude
Descubre el retículo endoplásmico -
Erwin llega
Se publica la composición del ADN. -
David Norton Zinder y Joshua Lederberg
Informe del descubrimiento de un mecanismo de transferencia genética que le dan el nombre "transducción. " -
Renato Dulbecco
Placas virales método para la producción de placas virales en monocapas de células en cultivo de tejidos (cultivo de células). -
Claes Weibull
Descubrimiento de Protoplastos -
S. A. Zahler y James W. Moulder
-
C. F. Robinow y R. G. E Murray
-
Frederick Sanger
Completa el análisis de la secuencia de aminoácidos y la estructura de las cadenas polipeptídicas de la insulina. -
A. y S. R Howard. Pelc
Muestran que la replicación del ADN tiene lugar sólo durante la fase S y que existe una brecha (G2) entre la síntesis y la mitosis (M) y otra pausa (Gt) entre M y S. -
M. A. Timp y Ernest H. Runyon
Mycobacterias atípicas (tuberculosis) -
Ciclo de Calvin.
Melvin Calvin, en colaboración con J.A. Bassham, A. A. Benson. -
John F. Enders y Thomas C. Peebles
-
J. P. Duguid, I. W. Smith, G. Dempster, y P. N. Edmunds
-
M . R . J. Salton
Descubre que las paredes celulares bacterianas hay N-acetilglucosamina y ácido N-acetilmurámico -
Christian de Duve
Descubre los lisosomas y los peroxisomas -
Seymour Benzer
Introduce el término "cistrón" para describir la secuencia más corta de ADN que funciona como un gen. -
A. Gierer y Gerhard Felix Schramm, Heinz Fraenkel Conrat
Muestran que el ácido ribonucleico aislado del virus del mosaico del tabaco es infeccioso -
Francois Jacob, y William Hayes
Concluyen que el cromosoma de Escherichia coli es circular. -
Herbert F. Copeland
Sugiere la clasificación de los organismos en cuatro reinos: monera, protista, animalia y plantae -
Elliot Volkin y Lázaro Astxachan.
Descubre el ARN mensajero -
Francis Crick
Descubre ARN de transferencia -
George Emile Palade
Descubre los Ribosomas -
Tang y compañeros de trabajo
Aíslan el agente causante del tracoma. -
Edouard Kellenberger y Antoinette Ryter
Publican fotografías (microscopio electrónico) muestran claramente que la pared celular bacteriana y la membrana son estructuras separadas. -
CE Dougherty
Propone los términos "procariotas" y "eucariota" para diferenciar las bacterias y "algas azul-verde" de todos los otros tipos de células. -
Mateo Stanley Meselson y Franklin William Stahl
Proporcionan una prueba experimental de que el ADN en Escherichia coli se duplica durante la división llamada "replicación semiconservativa". -
Francois Jacob y Jacques Monod, con David Perrin y Carmen Sánchez.
Proponen el concepto del "operón" para explicar la regulación de la síntesis de proteína. -
François Jacob y Jacques Monod proporcionan el modelo operón
-
ET Bolton y McCarthy Brian J. desarrollan un método general para el aislamiento de RNA que es complementaria a regiones específicas de ADN
-
Se observa la forma de la ADN bajo un microscopio de luz, revelando que el ADN bacteriano es una molécula circular
-
Nirenberg informa que trinucleótidos causan la unión de un solo amino ácido a los ribosomas, probando así que el código es tres nucleótidos.
-
Robert Bruce Merrifield desarrolla un método en fase sólida para la síntesis de polipéptidos y proteínas.
-
TF Roth y DR Helinski muestran que un factor que controla la producción colicina, un factor de Col, es una forma circular del ADN.
-
Donald F. Summers y Jacob V. Maizel, Jr. Ellos sugieren que algunos de los productos de traducción primarios son procesados para formar productos secundarios de tamaño más pequeño.
-
Don J. Brenner, Stanley Falkow, estudian las relaciones taxonómicas entre los enterobacterias mediante la medición del grado de reasociación de extraído de una especie con la de una segunda especie.
-
Albert Victor Crewe construye el primer microscopio electrónico de barrido.
-
Har Gobind Khorana y colegas muestran métodos químicos para sintetizar el gen de levadura alanina ARN de transferencia
-
Eva Engvall Peterman desarrolla el ensayo de inmunoabsorción enzimática conocida como ELISA. En esta técnica, ya sea el anticuerpo o antígeno se adjunta a un portador insoluble mientras que la del lado opuesto reactivo se une a una enzima.
-
S. Jonathan Singer y Garth Nicolson proponer un modelo de la estructura de las membranas en una bicapa lipídica que contiene proteínas que no se encuentran en una capa continua.
-
Stanley N. Cohen, Annie C. Y. Chang, Herbert W. Boyer, y Robert B. Helling crean un plásmido híbrido que se introducen en las células de Escherichia coli
-
Roger D. Kornberg, informa de que la estructura de la cromatina se basa en una unidad repetitiva de cada uno de los cuatro tipos principales de la histona asociada con alrededor de 200 pares de bases de ADN.
-
Carl R. Woese y George E. Fox redefinen la clasificación de las bacterias. Llevan a cabo la catalogación de las moléculas de RNAr 16S mediante la digestión con ribonucleasa Tl. Proponen dos dominios, procariotas y eucariotas
-
Alec Jeffreys John y Richard Anthony Flavell encuentran una secuencia de 600 pares de bases en el gen de globina en conejos que es no codificante. Las secuencias no codificantes son llamadas intrones, mientras que las secuencias de ADN que codifica se conocen como exones.
-
Ortwin Meyer y Hans Gunter Schlegel aislaron una bacteria cuya fuente de carbono es el CO. Les asignan el nombre de Pseudomonas carboxydovorans. Se cree que desempeñan un papel importante en el mantenimiento de los niveles de CO atmosféricos.
-
Hemaglutinina picos se designan "H", mientras que los picos de la neuraminidasa se designan "N."
-
Proponen una vía de la síntesis de hidratos de carbono a partir de acetil coenzima A.
-
Martin W. Smith y Frederick C. Neidhardt, en experimentos con Escherichia coli, encontraron diferencias importantes en los polipéptidos sintetizados bajo condiciones aeróbicas y los sintetizados bajo condiciones anaeróbicas.
-
Wolfram Zillig y colegas nombrar dos nuevos géneros de Archaebacteria: Thermofilum y Thermococcus. Ambos se caracterizan por carecer de ácido murámico en sus paredes celulares
-
Jan A. Hobot y colaboradores concluyen que el espacio entre la membrana externa y la membrana plasmática se puede llenar con peptidoglicano en la forma de un gel.
-
Se diagnostica “la enfermedad de las vacas locas”
-
Powell, Beachy y compañeros muestran que las plantas transformadas genéticamente son resistentes a virus del mosaico del tabaco.
-
Kary Mullis y Faloona Fred A. describen una reacción en cadena de la polimerasa (PCR) amplifica exponencialmente una que secuencia de ácido nucleico in vitro.
-
Describen que las moléculas de rRNA, obtenidos a partir de arqueobacterias, eubacterias y eucariotas, pueden ser identificados a través de la unión de la sonda apropiada específica
-
Carl R. Woese, Otto Kandler, y Mark L. Wheelis proponen un nuevo sistema de clasificación de los organismos basados en la comparación de las secuencias de nucleótidos de ARN ribosomal: Eucarya, bacterias y arqueas
-
The following fields need your attention:
- Last date is same as or before first date
-
Edmond H. Fischer y Edwin G. Krebs descubren de las proteincinasas enzimas que regulan el crecimiento celular
-
Richard J. Roberts descubrimiento de que un gen puede separarse en segmentos diferentes de DNA
-
Kary B. Mulis Descubrimiento del PCR
-
Se observa la forma de la ADN bajo un microscopio de luz, revelando que el ADN bacteriano es una molécula circular.
-
Se secuencia el genoma de la bacteria Haemophilus influenzae
-
Peter C. Doherty descubrimiento de como las células T citotóxicas reconocen las células infectadas por virus antes de su destrucción
-
se secuencia el genoma de saccharomyces cerevisiae
-
Stanley Prusiner
escubrimiento de los priones -proteínas renegadas o infecciosas- como gentes causantes de la célebre enfermedad e las vacas locas, entre otras enfermedades neurodegenerativas. -
Se secuencia el genoma de Escherichia coli. se tiene al momento, del orden de 600 promotores -sitios de inicio de la transcripción- mapeados en el genoma y del orden de 300 operones o unidades de transcripción definidas
-
Heide H. Schulz se descubre la bacteria gigante thiomargarita namibiensis, tambien llamada la perla de azufre. Es tan grande que se puede ver a simple vista, sin ayuda de un microscopio. Algunas alcanzan los 0,75 milímetros de diámetro.
-
Heidelberg y Col. completaron el genoma de la bacteria gram negativa, gamma-Proteobacterium Vibrio cholerae, y descubrieron que estaba compuesto por dos cromosomas circulares de 2.961.146 pb y 1.072.314 pb.
-
Hopwood y Col. Realizaron la secuenciación del genoma de Streptomyces coelicolor el cual es un representante del grupo de bacterias filamentosas, viven en el suelo responsable de producir la mayoría de los antibióticos naturales utilizados en la medicina humana y veterinaria
-
Se completó el Proyecto Genoma Humano
se logro identificar los aproximadamente 100.000 genes humanos en el DNA. asi mismo determinar la secuencia de 3 billones de bases químicas que conforman el DNA -
es secuenciado el genoma de la bacteria causante de la legionelosis, legionella pneumophila, es un patógeno ambiental, una bacteria oportunista que habita en ambientes acuáticos y en el suelo, y la mayor fuente de contagio son los sistemas de agua
-
Barry Marshall descubre que la inflamación del estómago, o gastritis, así como la úlcera de estómago o duodeno, o enfermedad ulcerosa péptica, eran el resultado de una infección del estómago causada por la bacteria Helicobacter pylori.
-
Markiyan Oliynyk y col. Secuencian el genoma de Saccharopolyspora erythraea, que produce eritromicina, es conocido por la producción del antibiótico macrólido eritromicina, el cual actua contra diversas infecciones de bacterias.
-
Descubren una bacteria Desulforudis audaxviator la cual vive en un medio en el que hay unos 60 grados de temperatura y al que por supuesto no llega la luz solar. esta bacteria forma su propio ecosistema
-
Jaydip Ghosh y col. Descubren el proceso de esporulación en Mycobacterium la cual está formado por bacilos aerobios inmóviles, algunos de los cuáles son patógenos que causan graves enfermedades en los mamíferos, incluyendo tuberculosis y lepra.
-
caracterización “in vivo” e “in vitro” del virus H1N1
-
Implantes de corazón a medida por impresión 3D. Los investigadores han usado imágenes del corazón de distintos animales para crear una maqueta del órgano usando una impresora 3D.
-
En un intento de proteger a sus ciudadanos de la ciudad establece una política que nadie puede entrar en la ciudad hasta que haya transcurrido un período de espera determinado. El período de espera de 40 días es el origen de la palabra "cuarentena" (Quaranta italiano). Aunque la razón para elegir el período de 40 días no se conoce.
-
cientificos estadounidenses presentan una cura para el MERS (síndrome respiratorio por coronavirus de Oriente Medio) en ratones. también cómo prevenir la enfermedad y tratarla de forma eficaz a los ratones infectados.
-
Giovanni Faber utiliza la palabra "microscopio”
-
Microscopia. Antony van Leeuwenhoek, es el primero en ver y describir protozoos, de los cuales dijo: "animaitos muy pequeños". También ve un alga verde, posiblemente Spirogyra y glóbulos rojos en la sangre humana, y señaló que causan el enrojecimiento de
sangre. -
Anton van Leeuwenhoek realizo posiblemente la primera observación microscópica de bacterias examinando una preparación de agua pimienta con un microscopio.
-
Denys Papin describe un precursor de la autoclave cuando detalla de un "motor para huesos suaves " que utiliza para obtener la gelatina de huesos de animales.
-
Carolus Linnaeus amplía su sistema de nomenclatura binomial y clasificación de las plantas mediante el establecimiento no sólo las especies y géneros, sino también clases y órdenes.
-
Bory de San Vicente incluye una tabla titulada “Tableau des Ordes, des Familias et des Géneros de Microscopiques” en su libro Myclogia Europia. En donde enumera varios organismos, de los cuales ahora se sabe que son bacterias. Estos incluyen Espirilla y Vibrio.
-
Ferdinand Cohn utiliza colorantes como el carmín y hematoxilina para marcar secciones histológicas.
-
Charles Darwin publica El origen de las especies por medio de la selección natural , que culminó con más de 20 años de estudio.
-
Se publica el primer analisis del crecimiento bacteriano por Robert Buchanan
-
Maximilian Perty crea un género llamado Sporonema y formula una clasificación de bacterias ya sea como espiral o rectos y flexuosa o no.
-
Alcohol Destilado de los químicos del vino árabes aprender a destilar el vino para hacer el alcohol.